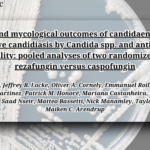

Valuable researchers have uncovered promising insights into combating Clostridioides difficile infection (CDI), a leading cause of healthcare-associated infections. The study reveals that a naturally avirulent C. difficile strain, ST1-75, can protect against CDI by outcompeting virulent strains such as R20291.
In mouse models, ST1-75 demonstrated remarkable protective effects, not only preventing colitis but also persisting after antibiotic treatments to provide long-term defense. The key lies in its unique metabolic advantage—ST1-75 rapidly depletes amino acids, creating an environment where virulent strains struggle to thrive. Interestingly, when amino acids were supplemented, this protective effect diminished, highlighting nutrient depletion as a critical mechanism in controlling CDI.
This groundbreaking discovery suggests that ST1-75 could serve as a cost-effective biotherapeutic agent, potentially preventing primary CDI in high-risk patients, offering an innovative approach beyond current therapies focused on recurrent infections.